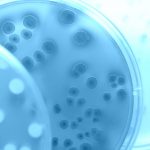

This week’s news health roundup consists of stories regarding gluten-free diet, vitiligo, E.coli, multiple sclerosis, rheumatoid arthritis, and fibromyalgia. We learned that a gluten-free diet may help with vitiligo, the similarities and differences between norovirus and E.coli, MS-related brain inflammation and rheumatoid arthritis links with depression, and increased risk of stroke and coronary heart disease in fibromyalgia patients.
 Can gluten-free diet cure vitiligo?
Can gluten-free diet cure vitiligo?
Can a gluten-free diet cure vitiligo? Well, we know that a gluten-free diet is recommended for those who suffer from celiac disease as they have intolerance to gluten. Both celiac disease and vitiligo are autoimmune diseases, and in vitiligo, the skin pigment is lost causing lighter patches. In cases where the two conditions occur together, there is evidence that sticking to a gluten-free diet not only aids in celiac disease but can help with vitiligo, too.
Advertisement
While the effects of vitiligo are not life-threatening, the skin condition can have psychological and social implications depending on where the pigment is lost on the body. Vitiligo affects roughly one percent of the population, and although it is not contagious, vitiligo patients feel somewhat stigmatized.
Research has shown that celiac disease and vitiligo originate from the same family of autoimmune disorders. There are 14 known genes that have been associated with vitiligo, and 13 of them have been found to play a role in celiac disease as well. In an alternative study, researchers examined blood samples of vitiligo patients and found antibodies that also indicate celiac disease. Continue reading…
Norovirus vs. E. coli: Causes, symptoms, risk factors, and complications
Norovirus vs. E. coli: Causes, symptoms, risk factors, and complications
This year so far has been quite abundant in norovirus and E. coli outbreaks affecting cruise ships, schools, restaurants, and even popular food companies. Here are some highlights of those many norovirus and E. coli incidences.
Back in late 2015, a Chipotle restaurant had an outbreak, which was confirmed to be caused by norovirus. Nearly 120 people became sick after eating at a Chipotle in Boston.
Earlier in 2015, Chipotle also had an E.coli outbreak, which led many who got sick during the later outbreak to believe that is what got to them. Based on symptoms of those who ate at Chipotle and patterns that experts identified, they confirmed that the illness was not E.coli related, but rather due to norovirus.
During inspection, Chipotle was asked to temporarily close after officials found that chicken was being kept at a too low temperature and that employees were working while clearly showing the signs of illness. Continue reading…
 Multiple sclerosis-related brain inflammation may be causing depression: Study
Multiple sclerosis-related brain inflammation may be causing depression: Study
Multiple sclerosis-related brain inflammation may be causing depression, according to research. Higher rates of depression have been seen among multiple sclerosis patients – compared to the general population. Abnormal immune response, one of the characteristic symptoms of multiple sclerosis, has been linked to depression, too. Researchers believe this could be a shared pathological mechanism, which helps explain the association between multiple sclerosis and depression rates.
The findings add evidence to support that inflammation of the hippocampus alters its function and contributes to depressive symptoms. Hippocampus is associated with depression maintenance and multiple sclerosis pathology.
The researchers combined two complementary brain imaging techniques to study the relationship between the hippocampal immune response, functional connections, and depressive symptoms in 13 multiple sclerosis patients and 22 healthy controls. The imaging techniques included positron emission tomography (PET) and functional magnetic resonance imaging (fMRI).
PET imaging revealed immune activation in the hippocampus, explained first author Dr. Alessandro Colasanti. He added, “We also discovered that more inflammation was associated to more severe symptoms of depression.” Continue reading…
 Rheumatoid arthritis and insomnia linked to depressive symptoms, fatigue, and disability
Rheumatoid arthritis and insomnia linked to depressive symptoms, fatigue, and disability
Rheumatoid arthritis (RA) and insomnia linked to depressive symptoms, fatigue, and disability. The findings of the study suggest that addressing sleep issues in rheumatoid arthritis patients may improve depressive symptoms, fatigue, and disability.
The study was a cross-sectional examination of the relationship between sleep quality and rheumatoid arthritis, involving 162 rheumatoid arthritis patients.
The participants completed the following questionnaires: Pittsburgh Sleep Quality Index (PSQI), Beck Depression Inventory-II, Medical Outcomes Study Short Form – 36, and the Health Assessment Questionnaire. The results provided input on their sleep quality, depression, fatigue, and functional disability and pain severity, respectively. Patients also provided sociodemographic information and their medical history.
Lead author Dr. Faith S. Luyster said, “The primary finding of our study is that poor sleep quality is associated with greater functional disability among patients with RA, and this relationship may be explained by pain severity and fatigue. These results highlight the importance of addressing sleep complaints among patients with RA. By treating sleep problems, either pharmacologically or behaviorally, symptoms and activity limitations associated with RA may be reduced.” Continue reading…
 Fibromyalgia associated with coronary heart disease and stroke risk: Study
Fibromyalgia associated with coronary heart disease and stroke risk: Study
Fibromyalgia is associated with the risk of coronary heart disease and stroke, according to research. The researchers arrived at this conclusion by comparing fibromyalgia patients to individuals without the condition.
In fibromyalgia – a chronic disorder characterized by widespread musculoskeletal pain – patients may also experience heart palpitations, chest pains, and heartburn. Unfortunately, these symptoms often go overlooked, especially if there is no current or past history of heart problems. The researchers in Taiwan have found that fibromyalgia patients have a higher risk of heart disease based on information from the Longitudinal Health Insurance Database.
Advertisement
There are many factors that could contribute to this increased risk of heart disease in fibromyalgia. Some researchers believe it may be a result of genetics, while others believe the conditions contributes to greater health problems as it progresses. At this time, the researchers have only found an association between fibromyalgia and heart disease, and not a cause-and-effect relationship.
Women are more likely to develop fibromyalgia than men, and they experience different symptoms of heart disease than men. Because of this disparity, oncoming heart complications often go undiagnosed. Fibromyalgia on its own is still not well understood, so it makes treating and spotting other ailments even more difficult.
In an alternative study, fibromyalgia has also been found to be associated with a higher risk of stroke. Even after accounting for comorbidities, which could contribute to stroke, fibromyalgia still remained a large risk factor for a higher risk of stroke. Furthermore, age was found to have the biggest impact on the risk of stroke in fibromyalgia patients. The association between fibromyalgia and stroke was seen highest among younger patients rather than older ones. The researchers recommend that fibromyalgia patients be closely monitored for stroke risk factors. Continue reading…
